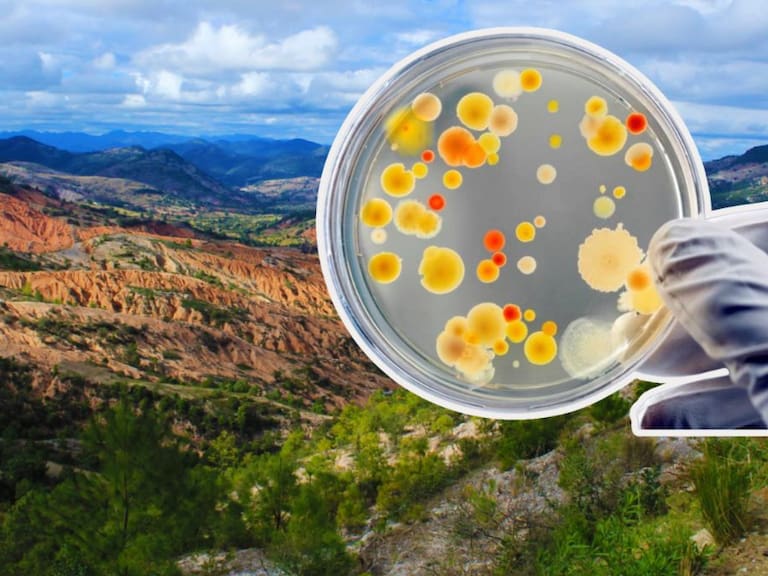
Este descubrimiento no solo aporta a la ciencia genómica, sino que también integra saberes ancestrales sobre el manejo del suelo. UNAM

Descubren en Oaxaca un “ejército de bacterias” que podrían transformar la agricultura
Científicos identificaron comunidades bacterianas que actúan de forma coordinada para defender plantas y estimular su crecimiento.
Este descubrimiento no solo aporta a la ciencia genómica, sino que también integra saberes ancestrales sobre el manejo del suelo. UNAM
Investigadores de la Universidad Nacional Autónoma de México (UNAM) dieron un paso importante hacia la agricultura sostenible tras identificar un “ejército de bacterias” benéficas en el Geoparque Mundial UNESCO Mixteca Alta, en Oaxaca.
Este hallazgo microbiano, descrito por científicos de la Unidad Académica de Estudios Territoriales (UAET), podría convertirse en una herramienta biotecnológica para mejorar suelos y reducir el uso de agroquímicos en cultivos tradicionales y modernos.
Las bacterias identificadas actúan de manera conjunta como un verdadero “ejército” natural al potenciar la fertilidad del suelo, facilitar el ciclado de nutrientes y suprimir organismos patógenos que afectan el crecimiento de plantas.
Te puede interesar: El Glaciar del Juicio Final podría colapsar: qué es y qué pasaría con la humanidad
Mediante secuenciación genética avanzada, el equipo científico determinó la presencia de grupos bacterianos dominantes con funciones clave para la restauración del terreno agrícola.
Entre las poblaciones detectadas están cepas pertenecientes a Proteobacteria, Actinobacteria, Acidobacteria y Chloroflexi, así como familias como Solibacteraceae y Sphingomonadaceae, las cuales participan en procesos que mejoran la estructura física del suelo, su estabilidad orgánica y la absorción de carbono y nitrógeno.
Este descubrimiento no solo aporta a la ciencia genómica, sino que también integra saberes ancestrales sobre el manejo del suelo, practicados por comunidades locales durante más de 3,400 años. Los sistemas agrícolas tradicionales como lama-bordos, terrazas y valles han favorecido el desarrollo de estas comunidades bacterianas, lo que sugiere que prácticas rurales milenarias pueden complementarse con tecnología moderna para producir soluciones agrícolas más eficientes y ecológicas.
Los expertos resaltan que este ejército microbiano podría ser la base para biofertilizantes y bioestimulantes naturales, ofreciendo a los agricultores opciones para reducir agroquímicos, recuperar suelos degradados y fortalecer la agricultura sostenible en México y el mundo.



